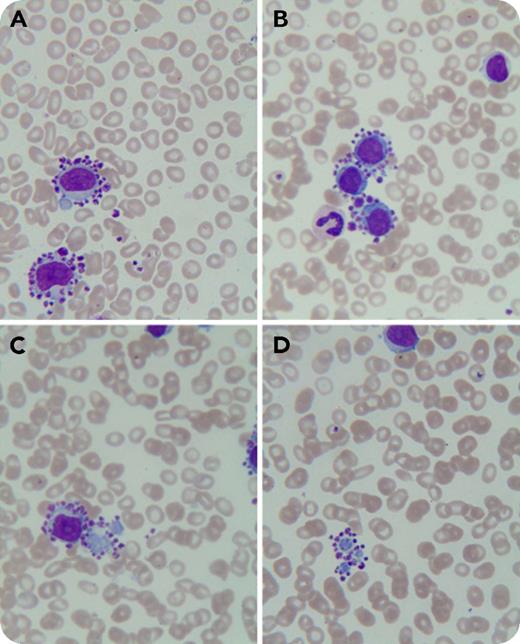
An 84-year-old woman presented to our institution with chest discomfort, dyspnea, and lower-extremity edema. She had undergone a percutaneous coronary intervention in 2013, and since then had been on clopidogrel bisulfate and aspirin therapy. Complete blood count showed: hemoglobin, 110 g/dL; white blood cell count, 13.49 × 109/L; and platelets, 137 × 109/L. A Wright-Giemsa–stained peripheral blood smear revealed 60% lymphocytes, with platelet satellitism almost exclusively around neoplastic lymphocytes (panels A-B; original magnification ×1000) and their cytoplasmic fragments (panels C-D; original magnification ×1000). Flow cytometry identified a monoclonal B-cell population of up to 27.8% that stained positive for surface markers CD19, CD20, CD22, FMC-7, CD23, CD25, CD103, CD200, and κ chain. The patient was diagnosed with B-cell lymphoproliferative disorder. Unfortunately, she had a hemorrhagic cerebral infarction and did not undergo further diagnostic workup and treatment. / Platelet satellitism around neutrophils is well recognized and is attributed to EDTA and its activation of platelets. Recently, it has been reported in lymphoid malignancies including mantle cell lymphoma and marginal zone B-cell lymphoma. Platelet satellitism around cytoplasmic fragments of neoplastic lymphocytes has not been reported. The present case may be due to aberrant surface molecules on neoplastic lymphocytes as a possible mechanism for platelet satellitism. Pseudothrombocytopenia may be present in patients with mild to moderate thrombocytopenia and lymphoid tumors.

An 84-year-old woman presented to our institution with chest discomfort, dyspnea, and lower-extremity edema. She had undergone a percutaneous coronary intervention in 2013, and since then had been on clopidogrel bisulfate and aspirin therapy. Complete blood count showed: hemoglobin, 110 g/dL; white blood cell count, 13.49 × 109/L; and platelets, 137 × 109/L. A Wright-Giemsa–stained peripheral blood smear revealed 60% lymphocytes, with platelet satellitism almost exclusively around neoplastic lymphocytes (panels A-B; original magnification ×1000) and their cytoplasmic fragments (panels C-D; original magnification ×1000). Flow cytometry identified a monoclonal B-cell population of up to 27.8% that stained positive for surface markers CD19, CD20, CD22, FMC-7, CD23, CD25, CD103, CD200, and κ chain. The patient was diagnosed with B-cell lymphoproliferative disorder. Unfortunately, she had a hemorrhagic cerebral infarction and did not undergo further diagnostic workup and treatment.
Platelet satellitism around neutrophils is well recognized and is attributed to EDTA and its activation of platelets. Recently, it has been reported in lymphoid malignancies including mantle cell lymphoma and marginal zone B-cell lymphoma. Platelet satellitism around cytoplasmic fragments of neoplastic lymphocytes has not been reported. The present case may be due to aberrant surface molecules on neoplastic lymphocytes as a possible mechanism for platelet satellitism. Pseudothrombocytopenia may be present in patients with mild to moderate thrombocytopenia and lymphoid tumors.
An 84-year-old woman presented to our institution with chest discomfort, dyspnea, and lower-extremity edema. She had undergone a percutaneous coronary intervention in 2013, and since then had been on clopidogrel bisulfate and aspirin therapy. Complete blood count showed: hemoglobin, 110 g/dL; white blood cell count, 13.49 × 109/L; and platelets, 137 × 109/L. A Wright-Giemsa–stained peripheral blood smear revealed 60% lymphocytes, with platelet satellitism almost exclusively around neoplastic lymphocytes (panels A-B; original magnification ×1000) and their cytoplasmic fragments (panels C-D; original magnification ×1000). Flow cytometry identified a monoclonal B-cell population of up to 27.8% that stained positive for surface markers CD19, CD20, CD22, FMC-7, CD23, CD25, CD103, CD200, and κ chain. The patient was diagnosed with B-cell lymphoproliferative disorder. Unfortunately, she had a hemorrhagic cerebral infarction and did not undergo further diagnostic workup and treatment.
Platelet satellitism around neutrophils is well recognized and is attributed to EDTA and its activation of platelets. Recently, it has been reported in lymphoid malignancies including mantle cell lymphoma and marginal zone B-cell lymphoma. Platelet satellitism around cytoplasmic fragments of neoplastic lymphocytes has not been reported. The present case may be due to aberrant surface molecules on neoplastic lymphocytes as a possible mechanism for platelet satellitism. Pseudothrombocytopenia may be present in patients with mild to moderate thrombocytopenia and lymphoid tumors.
For additional images, visit the ASH Image Bank, a reference and teaching tool that is continually updated with new atlas and case study images. For more information, visit http://imagebank.hematology.org.
This feature is available to Subscribers Only
Sign In or Create an Account Close Modal